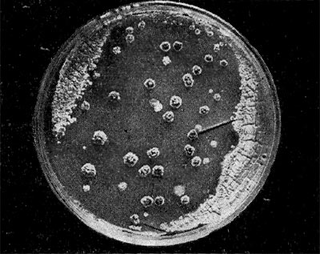

10399 (646494), страница 5
Текст из файла (страница 5)
Изменчивость фагов и изменчивость микроорганизмов под
влиянием фагов
Фаги, как и микроорганизмы, способны изменять все свои свойства: форму и размеры негативных колоний, спектр литического действия, способность к адсорбции на микробной клетке, устойчивость к внешним воздействиям, антигенные свойства. Особенно часто наблюдаются изменения морфологии негативных колоний, спектра литического действия и превращение умеренных фагов в вирулентные.
Большие изменения могут наблюдаться в тонкой структуре фаговой частицы — возникают дефектные частицы, лишенные головки, отростка, нитевидных образований или других субструктур.
Изменения фагов могут быть наследственными (мутации) и не наследственными (феноти-пические). Фенотипические изменения зависят от условий, в которых образуются фаговые частицы. Важное значение имеют изменения, вызываемые клеткой-хозяином, т.е. той культурой, на которой фаг размножается. Эти изменения большей частью носят фенотипический характер и касаются преимущественно формы негативных колоний, спектра литического действия и вирулентности. Под влиянием клетки-хозяина возможны и стойкие изменения типа мутаций. С помощью разных мутагенных факторов (лучистой энергии, химических агентов) могут быть получены разнообразные мутанты.
Особый интерес представляют изменения, происходящие при одновременном размножении на одной и той же культуре двух родственных по антигенным свойствам фагов. При этом в потомстве возникают частицы каждого из этих фагов и, кроме того, формы, которые приобрели свойства обоих родителей (гибридные формы).
Под влиянием фагов могут существенно изменяться все свойства микроорганизмов — морфология клеток, строение колоний, токсичность, подвижность и т.д. Изменения, вызываемые фагом, могут быть наследственными и ненаследственными. Механизмы, приводящие к изменению клеток под влиянием фагов, различные. В отдельных случаях фаг играет лишь роль отбирающего фактора: под его влиянием лизируются все чувствительные к нему клетки данной популяции и остаются лишь те клетки, которые еще до воздействия фагом были по разным причинам устойчивы к нему.
При выращивании микроорганизмов в жидкой среде совместно с активным против них фагом обычно наблюдается следующее. Сначала среда мутнеет, а затем просветляется в результате лизиса клеток. В ряде случаев через некоторое время (разное для разных микробов и фагов) культуральная жидкость снова мутнеет. Помутнение среды происходит вследствие возобновления роста культуры. На агаризованных средах при нанесении фага на газон чувствительной к нему культуры можно наблюдать вначале лизис культуры в местах нанесения фага, а через некоторое время на лизированных участках появляется рост культуры, обычно в виде отдельных колоний (рис. 218).
Вырастающие после лизиса микроорганизмы получили название культур вторичного роста. Анализ культур вторичного роста показывает, что в одних случаях они состоят из вариантов, ставших стабильно устойчивыми к данному фагу, в других — из нестойких форм. Культуры, ставшие устойчивыми к фагу, могут одновременно приобрести и ряд новых свойств. Этим обычно пользуются при получении фагоустойчивых культур для промышленных целей.
В последние годы были выявлены два принципиально различных механизма изменчивости клеток под влиянием фагов — трансдукция и лизогенные конверсии.
Трансдукция (перенос)
При размножении определенных умеренных фагов на чувствительних к ним культурах фаговая частица захватывает какой-нибудь фрагмент генетического материала данной клетки. При воздействии этим же фагом на другую чувствительную к нему культуру он передает новой культуре захваченный фрагмент. Культура, от которой фаг переносит генетический материал, получила название донора (дающая), а культура, приобретающая генетический материал, — реципиента (получающая).
При трансдукции фаг играет роль механического переносчика; лизогенизация клетки не обязательна. Один и тот же фаг может переносить разные свойства. Трансдукция происходит довольно редко: из одного и более миллионов фаговых частиц только одна способна осуществлять трансдукцию. При помощи трансдукции удавалось перенести от клеток-доноров клеткам-реципиентам различные свойства: токсичность, устойчивость к антибиотикам, способность продуцировать определенные ферменты, антигенные и другие свойства.
Лизогенные конверсии (превращения)
Как уже отмечалось, при лизогенизации клетка-хозяин приобретает устойчивость к данному фагу, а также способность продуцировать зрелые частицы этого фага. Однако этим не ограничиваются изменения, вызванные фагом при лизогенизации. Многочисленными опытами на микроорганизмах самых различных систематических групп было показано, что при лизогенизации клетка приобретает новые, точно определенные свойства, характер которых зависит от особенностей данного фага.
В отличие от трансдукции, при которой фаг выступает в роли механического переносчика генетического материала, при лизогенизации сам фаг (вернее, его нуклеиновая кислота) является тем генетическим материалом, который в виде профага придается генетическому материалу клетки. Поэтому при лизогенизации не имеет значения культура, на которой размножался данный умеренный фаг.
Наиболее детально лизогенные конверсии изучены у некоторых патогенных бактерий, преимущественно у дифтерийной палочки и сальмонелл.
Дифтерийная палочка содержит три разных фага. Оказалось, что только один из них (фаг бета) влияет на образование этой культурой токсина. При отсутствии в клетке фага бета культура не продуцирует токсина. Если нетоксичную дифтерийную культуру лизогенизировать фагом бета, то она приобретает способность образовывать токсин.
Иллюстрация 17: Появление колоний вторичного роста после лизиса актинофагом. Культура Act. oriental's продуцирует антибиотик ванкомицин
Опытами на сальмонеллах было показано, что токсичность, антигенный свойства, подвижность и другие признаки связаны с наличием в этих культурах строго определенных фагов. Среди споровых бактерий группы клостридий имеются виды, образующие ботулинический токсин, вызывающий опасные пищевые отравления. Недавно удалось выяснить, что эти культуры полилизогенные и один из содержащихся в них фагов вызывает образование токсина. Для ряда культур показано, что способность продуцировать определенные ферменты, антигенные и другие их свойства связаны с лизогенизацией определенными фагами. Была выявлена одна полилизогенная культура акти-номицета, которая содержала 4 разных фага. Из них один определял способность культуры продуцировать антибиотик. После удаления его культура теряла способность продуцировать антибиотик. При лизогенизации неактивной культуры этим фагом она вновь приобретала способность образовывать антибиотик.
К сожалению, еще у очень многих лизогенных культур микроорганизмов не установлено, какие свойства их связаны с фагами. Выяснение этого вопроса — одна из важнейших задач микробиологов и генетиков.
Практическое использование фагов
Первыми были выделены фаги, активные против патогенных микроорганизмов (дизентерийной палочки). Вполне естественно, что у исследователей многих стран возник вопрос об использовании фагов для лечения и профилактики инфекционных заболеваний, вызываемых бактериями (дизентерия, брюшной тиф, паратифы, холера и др.). Многочисленные исследования в этой области были проведены и в нашей стране. Результаты этих работ весьма разноречивы. Имеются данные, показывающие несомненную эффективность фагов при лечении дизентерии и холеры. Во время Великой Отечественной войны некоторые хирурги успешно применяли фаги для борьбы с нагноением ран. «Сталинский антибиотик»-Старое лекарство из красноармейского вещмешка может вернуться во врачебную практику.
В 30-х годах туберкулез и воспаление легких стали излечимыми, а гангрена перестала непременно заканчиваться ампутацией. Но врачи и фармацевты жарко спорили о том, какое антибактериальное средство эффективнее — антибиотики или бактериофаги.
Главным преимуществом пенициллина и его производных была возможность изготавливать их синтетическим путем. Изобретение Александра Флеминга тогда одержало победу. Массовая эйфория по поводу бактериофагов сменилась забвением.
Везде, кроме Советского Союза, где на родине Сталина, в Грузии, специальный медицинский институт продолжал соответствующие исследования. В результате родились противовоспалительные препараты, который широко использовались при самых разных диагнозах — от заражения крови до простуды.
Больше всего их применяли в Красной Армии, но они использовались и в гражданской медицине, как в СССР, так и в некоторых странах Восточной Европы.
До недавних пор использование бактериофагов считалось местной спецификой, если не признаком отсталости. Однако роман мировой медицины с антибиотиками начал подходить к концу по мере того, как микробы стали приобретать к ним устойчивость.
Чтобы создать новый сильнодействующий антибиотик, фармацевтические компании сегодня должны в среднем потратить 10 лет и 800 млн. долларов.
Начались лихорадочные поиски принципиально новых методов лечения. Похоже, возвращение бактериофагов не за горами.
Привлекательность антибиотиков, помимо всего прочего, состоит и в том, что одно и то же лекарство способно уничтожать разные бактерии. В случае с бактериофагами надо вывести отдельный вирус для каждого инфекционного заболевания.
Правда, бактерии могут приобрести устойчивость к отдельным фагам, как они уже научились сопротивляться антибиотикам. В этом случае придется создавать новые разновидности вирусов. Скорее всего, чтобы повысить эффективность лечения, будут использоваться «коктейли» из нескольких фагов.
Лечение бактериофагами не дает побочных эффектов. Правда, известно, что в 30-е и 40-е годы оно довольно часто не давало вовсе никакого эффекта, и пациенты умирали.
—Однако современные энтузиасты «нового старого» метода терапии убеждены, что дело не в его недостатках как такового, а в несовершенстве технологий более чем полувековой давности и неправильных диагнозах.
Рассмотрим роль бактериофагов в сохранении микробиоценоза человека и теплокровных животных.
На представленной схеме можно увидеть наличие на коже, в полости рта или в кишечнике различных видов микроорганизмов и их количественное соотношение. Здесь изображен один из вариантов правильного микробиоценоза, где присутствуют все представители микроорганизмов и каждый занимает свою определенную нишу.
Самый большой сектор - это бактерии нормофлоры, которые создают с организмом взаимовыгодное сосуществование. Человек для них является средой обитания, а бактерии участвуют во многих жизненно важных для организма процессах, связанных в первую очередь с обменом веществ.
Следующий по величине сектор - медиаторы - вещества, которые выделяют сами клетки кожи и все виды микроорганизмов. Это могут быть сигнальные белковые молекулы, лизоцим, витамины, молочная кислота, другие органические кислоты и т.д. Медиаторы являются одним из самых важных звеньев в существовании микробиоценоза и регулируют многие связи в организме.
Еще пять небольших секторов занимают грибы, вирусы, бактериофаги, простейшие и болезнетворные бактерии, типа стрептококков и стафилококков. При изменении этого соотношения или при исчезновении одного из "секторов" под воздействием неблагоприятных факторов возникают воспалительные процессы.
Уже с первых минут жизни человек или животное вступает в контакт с миром микроорганизмов и сосуществует с ним всю жизнь. Это взаимодействие бывает разным: полезное, взаимовыгодное сожительство называется симбиозом. В случае, когда наносится вред одному из "контактеров" - это паразитизм. Взаимодействие с некоторыми бактериями является крайне опасным (например, с палочкой чумного микроба, хотя летальный исход может наступить и от заражения крови обыкновенным стрептококком). В то же время без присутствия лактобактерий или бифидобактерий нарушаются многие функции слизистых оболочек и возникают заболевания. Эти бактерии находятся в симбиозе с организмом, а бактерии чумы - являются паразитами. Биологический термин "паразит" означает, что один живой организм живет и размножается за счет другого. Вид, используемый в качестве "добычи", называется, хозяином. Очень часто в природе такое взаимодействие заканчивается гибелью хозяина и увеличением численности паразита. Численность паразита в свою очередь ограничивает другой вид, для которого паразит является хозяином. Таким образом, паразит - биологический ограничитель. Именно существование биологических ограничителей обеспечивает гармонию в живой природе и сохранение всех биологических видов.
Биологическими ограничителями бактерий являются бактериофаги, в свою очередь,биологическими ограничителями фагов являются медиаторы выделяемые клетками кожи ,бактериями и грибами. Так замыкается круг.
Фаги, бактерии, грибы, простейшие, даже мелкие насекомые, типа клещей, могут быть легко обнаружены и уничтожены целой системой клеток кожи, тем не менее, этого не происходит. В здоровом состоянии все находится в гармонии, "все уживаются" друг с другом, а вот при нарушении этих взаимоотношений возникают проблемы, и приходится восстанавливать утраченное.
Таким образом, исчезновение бактериофагов из этой цепочки создаст условия для размножения болезнетворных бактерий, следовательно можно рассматривать фаги как один из методов, созданных самой природой для поддержания микробиоценоза организма человека или животных.
Бактериофаги – альтернатива антибиотикам
| Сравниваемые особенности | Антибиотики | Бактериофаги |
| Частота развития вторичной резистентности | От незначительной до очень высокой | Не характерно |
| Профилактическое использование | Неэффективно, противопоказано | Широко используется |
| Длительность создания нового препарата | От нескольких лет до десятилетий | От нескольких дней до нескольких месяцев |
| Сравниваемые особенности | Антибиотики | Бактериофаги |
| Концентрация в инфекционном очаге | Отличается для разных препаратов, зависит от локализации процесса, скорость снижения различна | Нарастает путем саморазмножения, снижается после ликвидации инфекции |
| Влияние на ферментные системы организма | Характерно для всех препаратов | Не описано |
| Наличие побочных эффектов и осложнений | Аллергические, токсические, конкурентные (в отношении прочих медикаментов), дизбиотичесике изменения различных органов, в том числе – тяжелые (псевдомембранозный колит, ассоциированный с Clostidium difficile)) | Не характерно. Редко - аллергические реакции. Могут вызывать реакцию высвобождения при массивном разрушении микробов. Дизбиотических нарушений не вызывают, но используются для их коррекции. |
| Рациональная комбинация с другими антибактериальными препаратами | Зависит от класса антибактериальных средств и может быть по типу суммации, потенцирования и т.д., в зависимости от точек приложения воздействия препарата на бактериальную клетку. | Всегда по типу взаимного потенцирования, по предварительным данным – вне зависимости от класса препарата. |
| Совместимость с другими медикаментами | Различная, (конкуренцией за ферментные системы, связывание с тканями, усиление токсических эффектов и пр.) | Полная, в том числе и с антибиотиками. |
| Активность в отношении патогенных микробов | Различная. Подавляюта облигатную флору организма, вызывая дисбиотические нарушения. Число чувствительных штаммов составляет 60-90%. | Число чувствительных штаммов составляет 70-90%. Не влияют на облигатную флору организма, не вызывают дизбиоз.. |
Применение препаратов бактериофагов при лечении